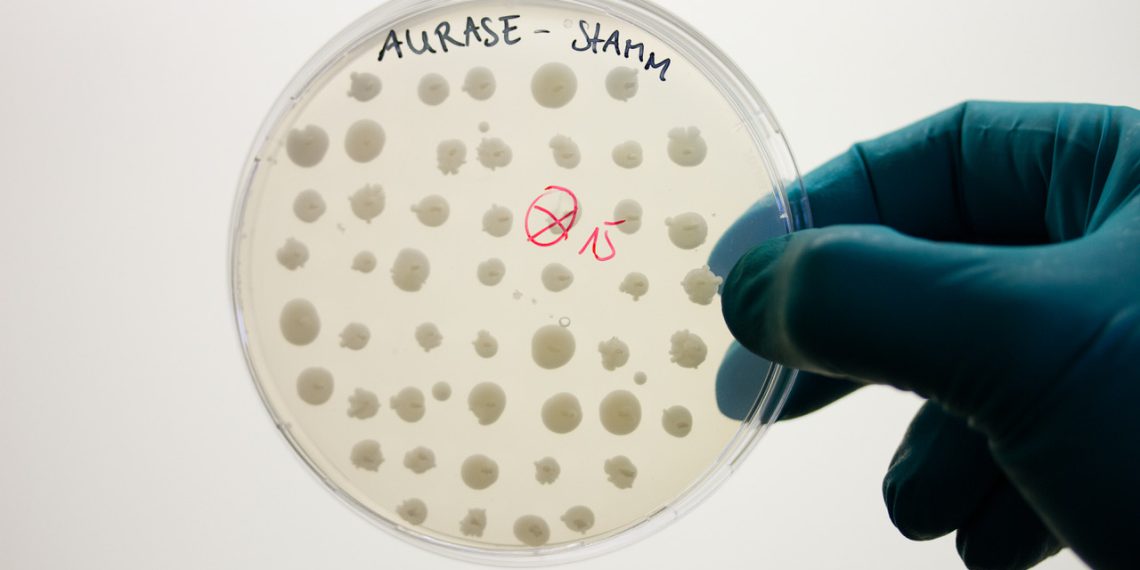
SolasCure Ltd. wird Medizinprodukte vermarkten, die auf dem neuen von der Brain AG entwickelten enzymatischen Wirkstoff Aurase beruhen.

Das Biotechnologieunternehmen Brain AG gibt die Beteiligung an der Gründung von SolasCure Ltd. bekannt. Die SolasCure Ltd. hat ihren Sitz im walisischen Cardiff (GB) und wird eigenverantwortlich Medizinprodukte zur biologischen Konditionierung chronischer Wunden, die auf dem von der Brain AG entdeckten neuartigen Wundreinigungsenzym Aurase beruhen, entwickeln sowie zu einer CE-Zertifizierung und Vermarktung führen.
In einer erfolgreichen Serie A Finanzierungsrunde haben sich Investoren, unter ihnen die Brain AG, an der SolasCure beteiligt. Das Unternehmen hat Patente zur Kommerzialisierung zukünftiger Aurase-basierter Produkte an das neue Unternehmen übertragen und wird darüber hinaus auch den neuartigen enzymatischen Wirkstoff bereitstellen.
Bei SolasCure handelt es sich um eine gemeinschaftliche Unternehmensgründung zusammen mit Dr. Sam Bakri. Dr. Bakri verfügt als Unternehmer über umfassende Erfahrung im Gesundheitswesen und wurde zum CEO ernannt. Professor Keith Harding (CBE), Gründer des Welsh Wound Innovation Centre und ausgewiesener Experte in der Wundbettvorbereitung, wurde zum Vorsitzenden des Medizinischen Beirates ernannt.
„Der Wirkstoff Aurase ist hochinnovativ und birgt großes Potenzial für das Gesundheitswesen. SolasCure fokussiert auf seine Weiterentwicklung, um unzähligen Patienten, die an chronischen Wunden leiden, schon bald eine Behandlung bieten zu können. Es ist uns gelungen, ein in der Entwicklung von Medizinprodukten zur Wundheilung erfahrenes Team unter der fachlichen Beratung von Keith Harding zusammenzubringen.“
Sam Bakri, Mitbegründer und CEO der SolasCure
Aurase ist umfänglich patentiert (WO 2010/099955). Grundlage der Aurase ist ein Protein abbauendes Enzym auf Grundlage natürlicher Ressourcen. Brain-Forschern haben ein Enzym identifiziert, das von der Made der Goldfliege abgesondert wird und nekrotisches Gewebe auflöst. Diese Protease wurde aus medizinisch genutzten Maden isoliert und kloniert. Unter der Anleitung des Unternehmens kann der enzymatische Wirkstoff biotechnologisch in GMP-Qualität hergestellt und an SolasCure zur weiteren Verarbeitung zum Medizinprodukt geliefert werden.
„Mit dem technologischen Know-how der Brain wurde die Aurase-Entwicklung bereits wesentlich vorangebracht. Um den Fortschritt zu beschleunigen und die relevante Zulassungs- und Marktexpertise zu bündeln, haben wir uns für die Ausgründung des Geschäfts unter Hinzunahme von Investoren und Experten ihres Fachs entschieden. Wir sind zuversichtlich, dass wir erste Aurase-enthaltende Medizinprodukte im Jahr 2021 in den Markt einführen und so auch die Geschäftsentwicklung der Brain AG weiter vorantreiben können.“
Frank Goebel, CFO der Brain AG und Mitglied des „Board of Directors“ der SolasCure
Durch die medizinische Nutzung von Aurase sollte die Wundkonditionierung beschleunigt und dadurch bessere Ergebnisse für Patienten sowie Kosteneinsparungen im Gesundheitswesen ermöglicht werden. Weltweit litten nach Auskunft von Global Industry Analysts Inc. im Jahre 2015 etwa 40,5 Mio. Patienten an chronischen Wunden, wie beispielsweise an diabetischem Fuß, Druckgeschwüren und anderen chronischen Wunden wie Ulcus curis. Mediziner gehen davon aus, dass diese Zahl in den nächsten Jahren aufgrund einer Zunahme von Diabetes Typ 2 sowie einer alternden Patientenpopulation steigen wird.